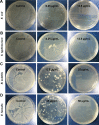
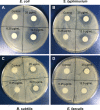

Graphene oxide-modified ZnO particles: synthesis, characterization, and antibacterial properties
- PMID: 26347126
- PMCID: PMC4554433
- DOI: 10.2147/IJN.S88319
Graphene oxide-modified ZnO particles: synthesis, characterization, and antibacterial properties
Abstract
Nanosized ZnO particles with diameters of 15 nm were prepared with a solution precipitation method at low cost and high yield. The synthesis of the particles was functionalized by the organic solvent dimethylformamide, and the particles were covalently bonded to the surface of graphene oxide. The morphology of the graphene oxide sheets and ZnO particles was confirmed with field emission scanning electron microscopy and biological atomic force microscopy. Fourier transform infrared spectroscopy and X-ray diffraction were used to analyze the physical and chemical properties of the ZnO/graphene oxide composites that differed from those of the individual components. Enhanced electrochemical properties were detected with cyclic voltammetry, with a redox peak of the composites at 0.025 mV. Excellent antibacterial activity of ZnO/graphene oxide composites was observed with a microdilution method in which minimum inhibitory concentrations of 6.25 µg/mL for Escherichia coli and Salmonella typhimurium, 12.5 µg/mL for Bacillus subtilis, and 25 µg/mL for Enterococcus faecalis. After further study of the antibacterial mechanism, we concluded that a vast number of reactive oxygen species formed on the surface of composites, improving antibacterial properties.
Keywords: ZnO; antibacterial property; characterization; graphene oxide.
Figures

References
-
- Varsha S, Deepak G, Yogesh CS. Synthesis, characterization and application of zinc oxide nanoparticles (n-ZnO) Ceram Int. 2013;39(8):9803–9808.
-
- Yang MQ, Xu YJ. Basic principles for observing the photo sensitizer role of graphene in the graphene semiconductor composite photocatalyst from a case study on graphene−ZnO. J Phys Chem C. 2013;117(42):21724–21734.
-
- Kavitha T, Gopalan AI, Lee KP, Park SY. Glucose sensing, photocatalytic and antibacterial properties of grapheme–ZnO nanoparticle hybrids. Carbon N Y. 2012;50(8):2994–3000.
-
- Khan Y, Durranib SK, Mehmood M, Ahmad J, Khan MR, Firdous S. Low temperature synthesis of fluorescent ZnO nanoparticles. Appl Surf Sci. 2010;257(5):1756–1761.
-
- Shi RX, Yang P, Dong XB, Ma Q, Zhang AY. Growth of flower-like ZnO on ZnO nanorod arrays created on zinc substrate through low-temperature hydrothermal synthesis. Appl Surf Sci. 2013;264:162–170.
Publication types
MeSH terms
Substances
LinkOut - more resources
Full Text Sources
Medical